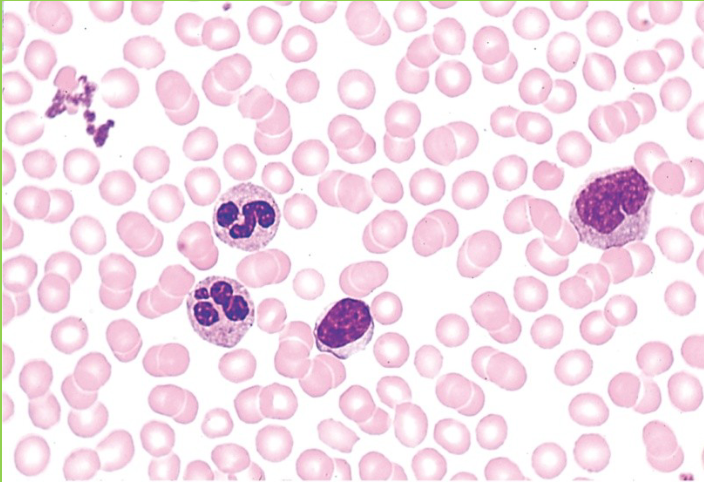

Lab Exercise 5- Histology/Tissue Slides
0.0(0)
Card Sorting
1/22
There's no tags or description
Looks like no tags are added yet.
Study Analytics
Name | Mastery | Learn | Test | Matching | Spaced |
|---|
No study sessions yet.
23 Terms
1
New cards
Simple Squamous

2
New cards
Simple Squamous in the Alveoli

3
New cards
Simple Cuboidal

4
New cards
Simple Columnar with Microvilli

5
New cards
Pseudostratified Ciliated Columnar

6
New cards
Keratinized Stratified Squamous

7
New cards
Non-Keratinized Stratified Squamous

8
New cards
Urothelium/Transitional Epithelial

9
New cards
Stratified Cuboidal

10
New cards
Loose Areolar Connective

11
New cards
Loose Reticular Connective

12
New cards
Dense Regular Connective

13
New cards
Dense Irregular Connective

14
New cards
Adipose

15
New cards
Hyaline Cartialge

16
New cards
Elastic Cartilage

17
New cards
Fibrocartilage

18
New cards
Osseous Tissue (Compact Bone in slide)

19
New cards
Fluid Connective (Blood)
20
New cards
Nervous Tissue

21
New cards
Skeletal Muscle

22
New cards
Cardiac Muscle

23
New cards
Smooth Muscle
